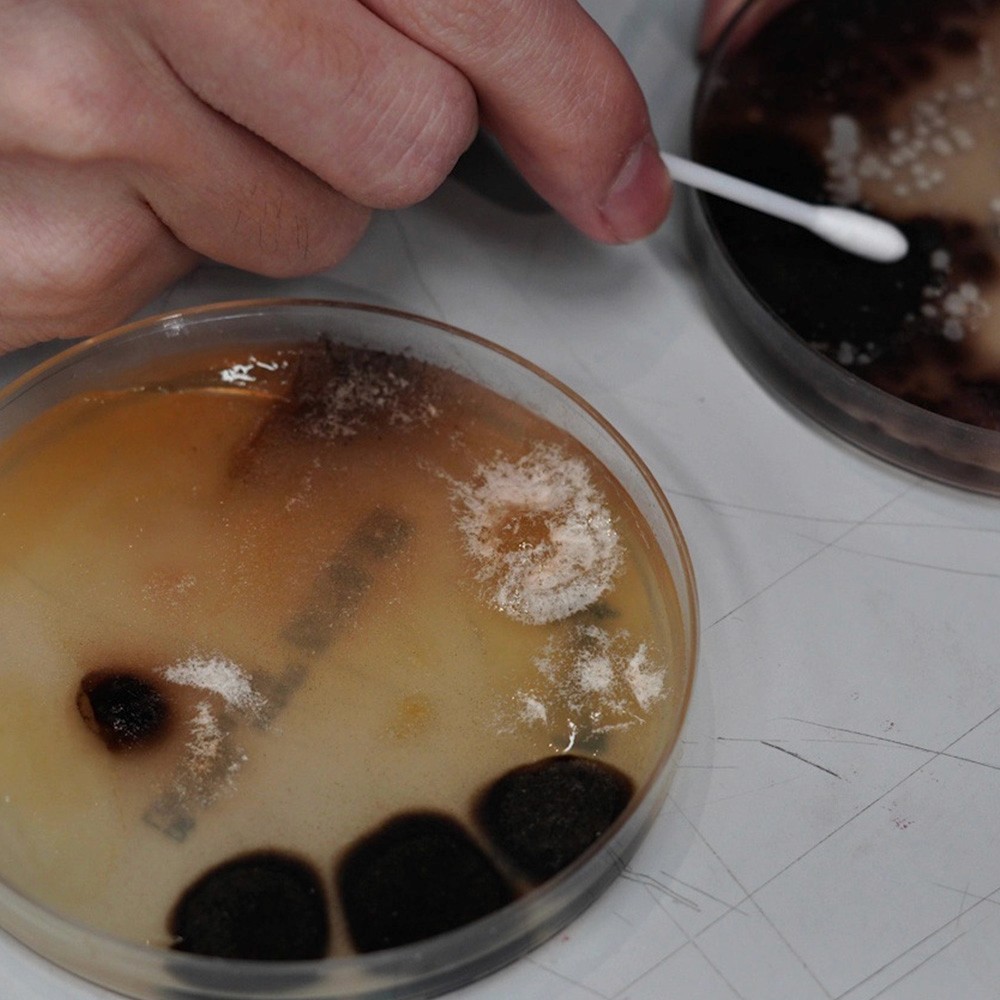
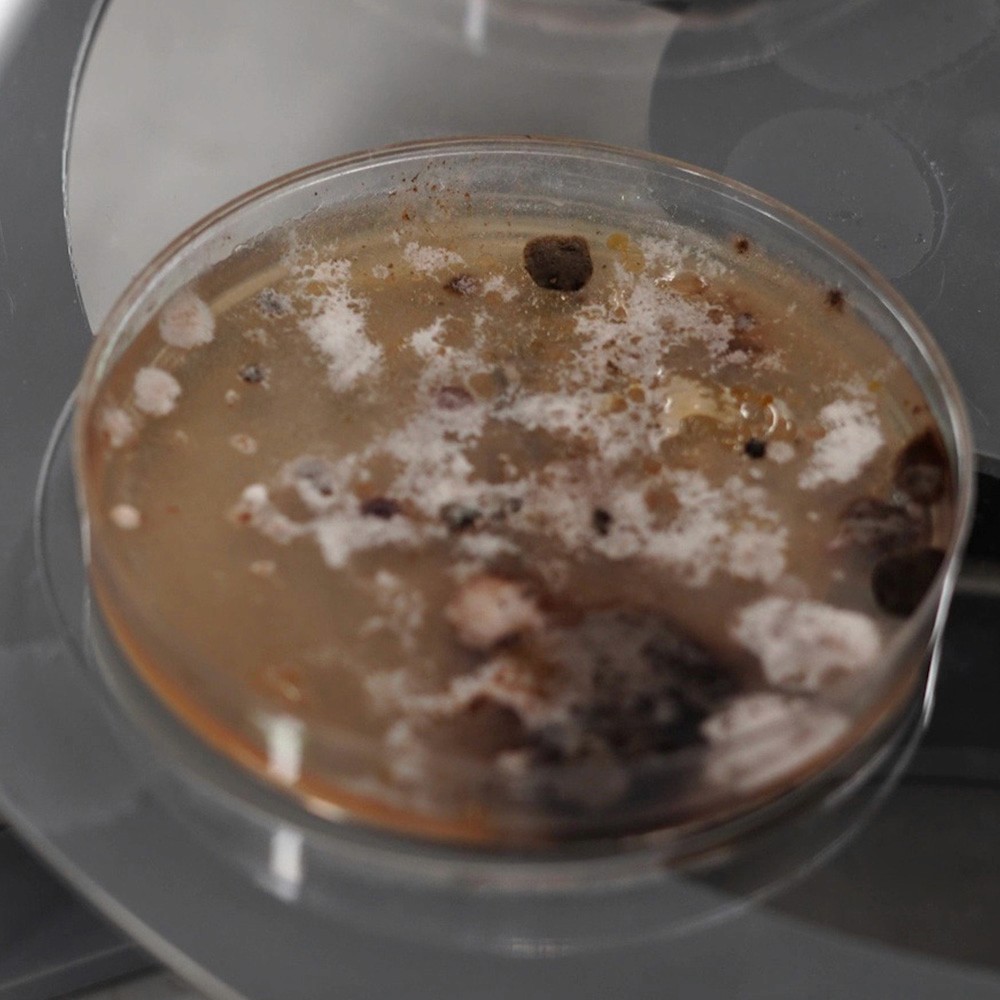
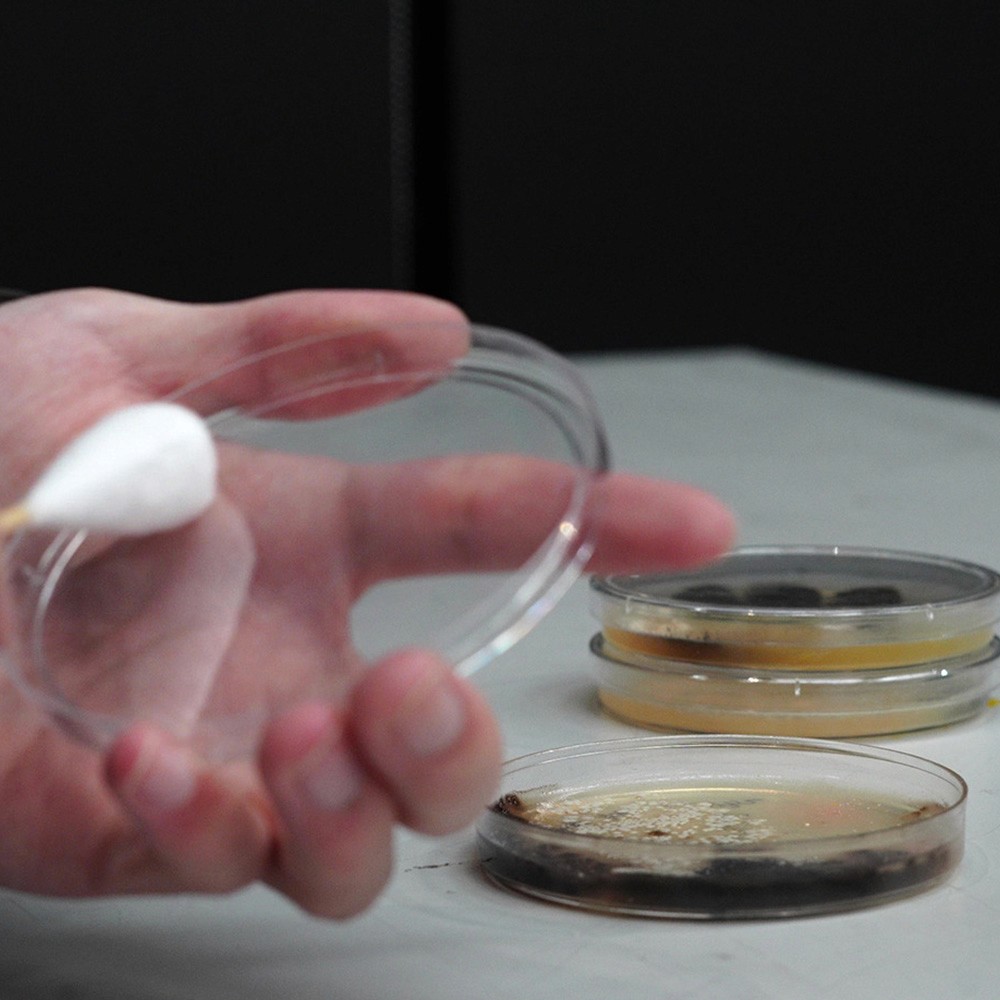
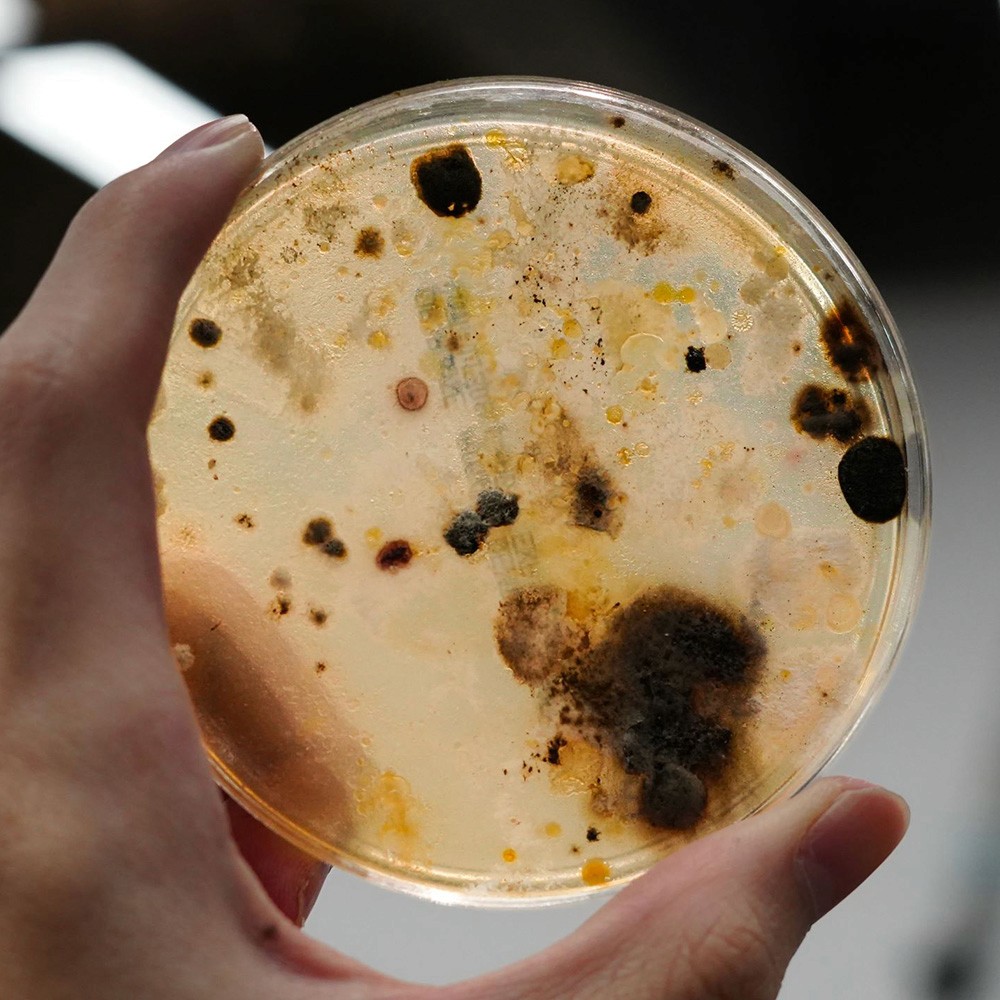

李家誠
李家誠
Motion Designer, Interactive Designer
生於2003年,擅長平面動態設計與互動藝術。探索動態之美時將虛實混合,並追尋純粹圖形帶來的視覺震撼與美感。
生於2003年,擅長平面動態設計與互動藝術。探索動態之美時將虛實混合,並追尋純粹圖形帶來的視覺震撼與美感。
個人網站

遞迴Recursion
遞迴Recursion
Touchdesigner、Arduino、馬達、培養皿
Touchdesigner、Arduino、馬達、培養皿
捕捉、培養、偵測、模擬。 建立一個現實與虛擬連結的生態圈,一個肆意生長的生態瓶。
捕捉、培養、偵測、模擬。 建立一個現實與虛擬連結的生態圈,一個肆意生長的生態瓶。

© SCCD WEB TEAM All Rights Reserved.








© SCCD WEB TEAM All Rights Reserved.

